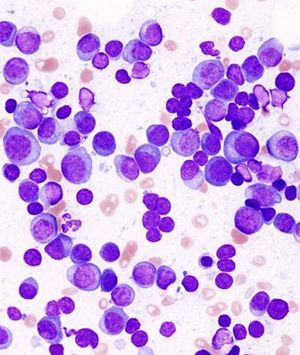

In patients with gastrointestinal cancers, factors such as younger age and comorbidities, among others, were significantly associated with a greater likelihood of sleep disturbance.

Your AI-Trained Oncology Knowledge Connection!


In patients with gastrointestinal cancers, factors such as younger age and comorbidities, among others, were significantly associated with a greater likelihood of sleep disturbance.

Darolutamide still has a favorable safety profile with prolonged treatment among patients with nonmetastatic castration-resistant prostate cancer.

Updated data from a phase 2 trial of apatinib added to single-agent chemotherapy for small cell lung cancer in patients with prior treatments indicate a good efficacy and safety for the combination.

Three abstracts reported at a medical meeting indicate that the combination of pembrolizumab plus lenvatinib is active in various gastrointestinal cancers.

Treatment with the combination of oral paclitaxel and encequidar was found to be associated with greater efficacy in patients with metastatic breast cancer, as well as lower rates of chemotherapy-induced peripheral neuropathy, compared to intravenous paclitaxel.

The telomerase inhibitor demonstrated improved overall survival spleen response, and symptom response in patients with myelofibrosis.

Carfilzomib combined with lenalidomide and dexamethasone failed to improve progression-free survival, compared with the current standard of care triplet of bortezomib, lenalidomide, and dexamethasone, in patients with newly diagnosed multiple myeloma.

Chemotherapy use in patients with lung and other thoracic cancers who are also diagnosed with COVID-19 was found to be associated with an increased risk of death compared to other treatment methods.

Published: December 5th 2020 | Updated:

Published: May 28th 2020 | Updated:
Published: May 29th 2020 | Updated:

Published: December 10th 2020 | Updated: